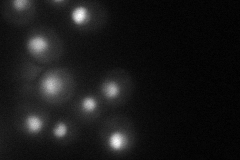
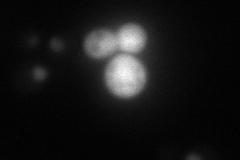
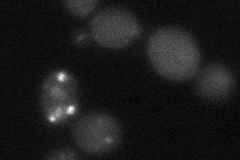

View description
Protein of unknown function, contains sequence that closely resembles a J domain (typified by the E. coli DnaJ protein)
Localization:
Intensity:
Fold change:
Significance:
-
C’ GFP library in SD

cytosol21.82 -
N' NOP1pr-GFP in SD
nucleolus53.0299 -
N' TEF2pr-mCherry in SD
nucleus22.8701 -
N' NATIVEpr-GFP in SD

below threshold15.4516 -
N' TEF2pr-VC and Cyto-VN in SD
below threshold26.1615 -
C’ GFP library in SD+DTT

cytosol22.61.03No -
C’ GFP library in SD+H2O2

cytosol17.210.78No -
C’ GFP library in Starvation Media

cytosol18.630.85No -
C’ GFP library on the background of Pup2-DaMP

cytosol -
C’ GFP library on the background of CCT mutant

cytosol18.84470.863379No
